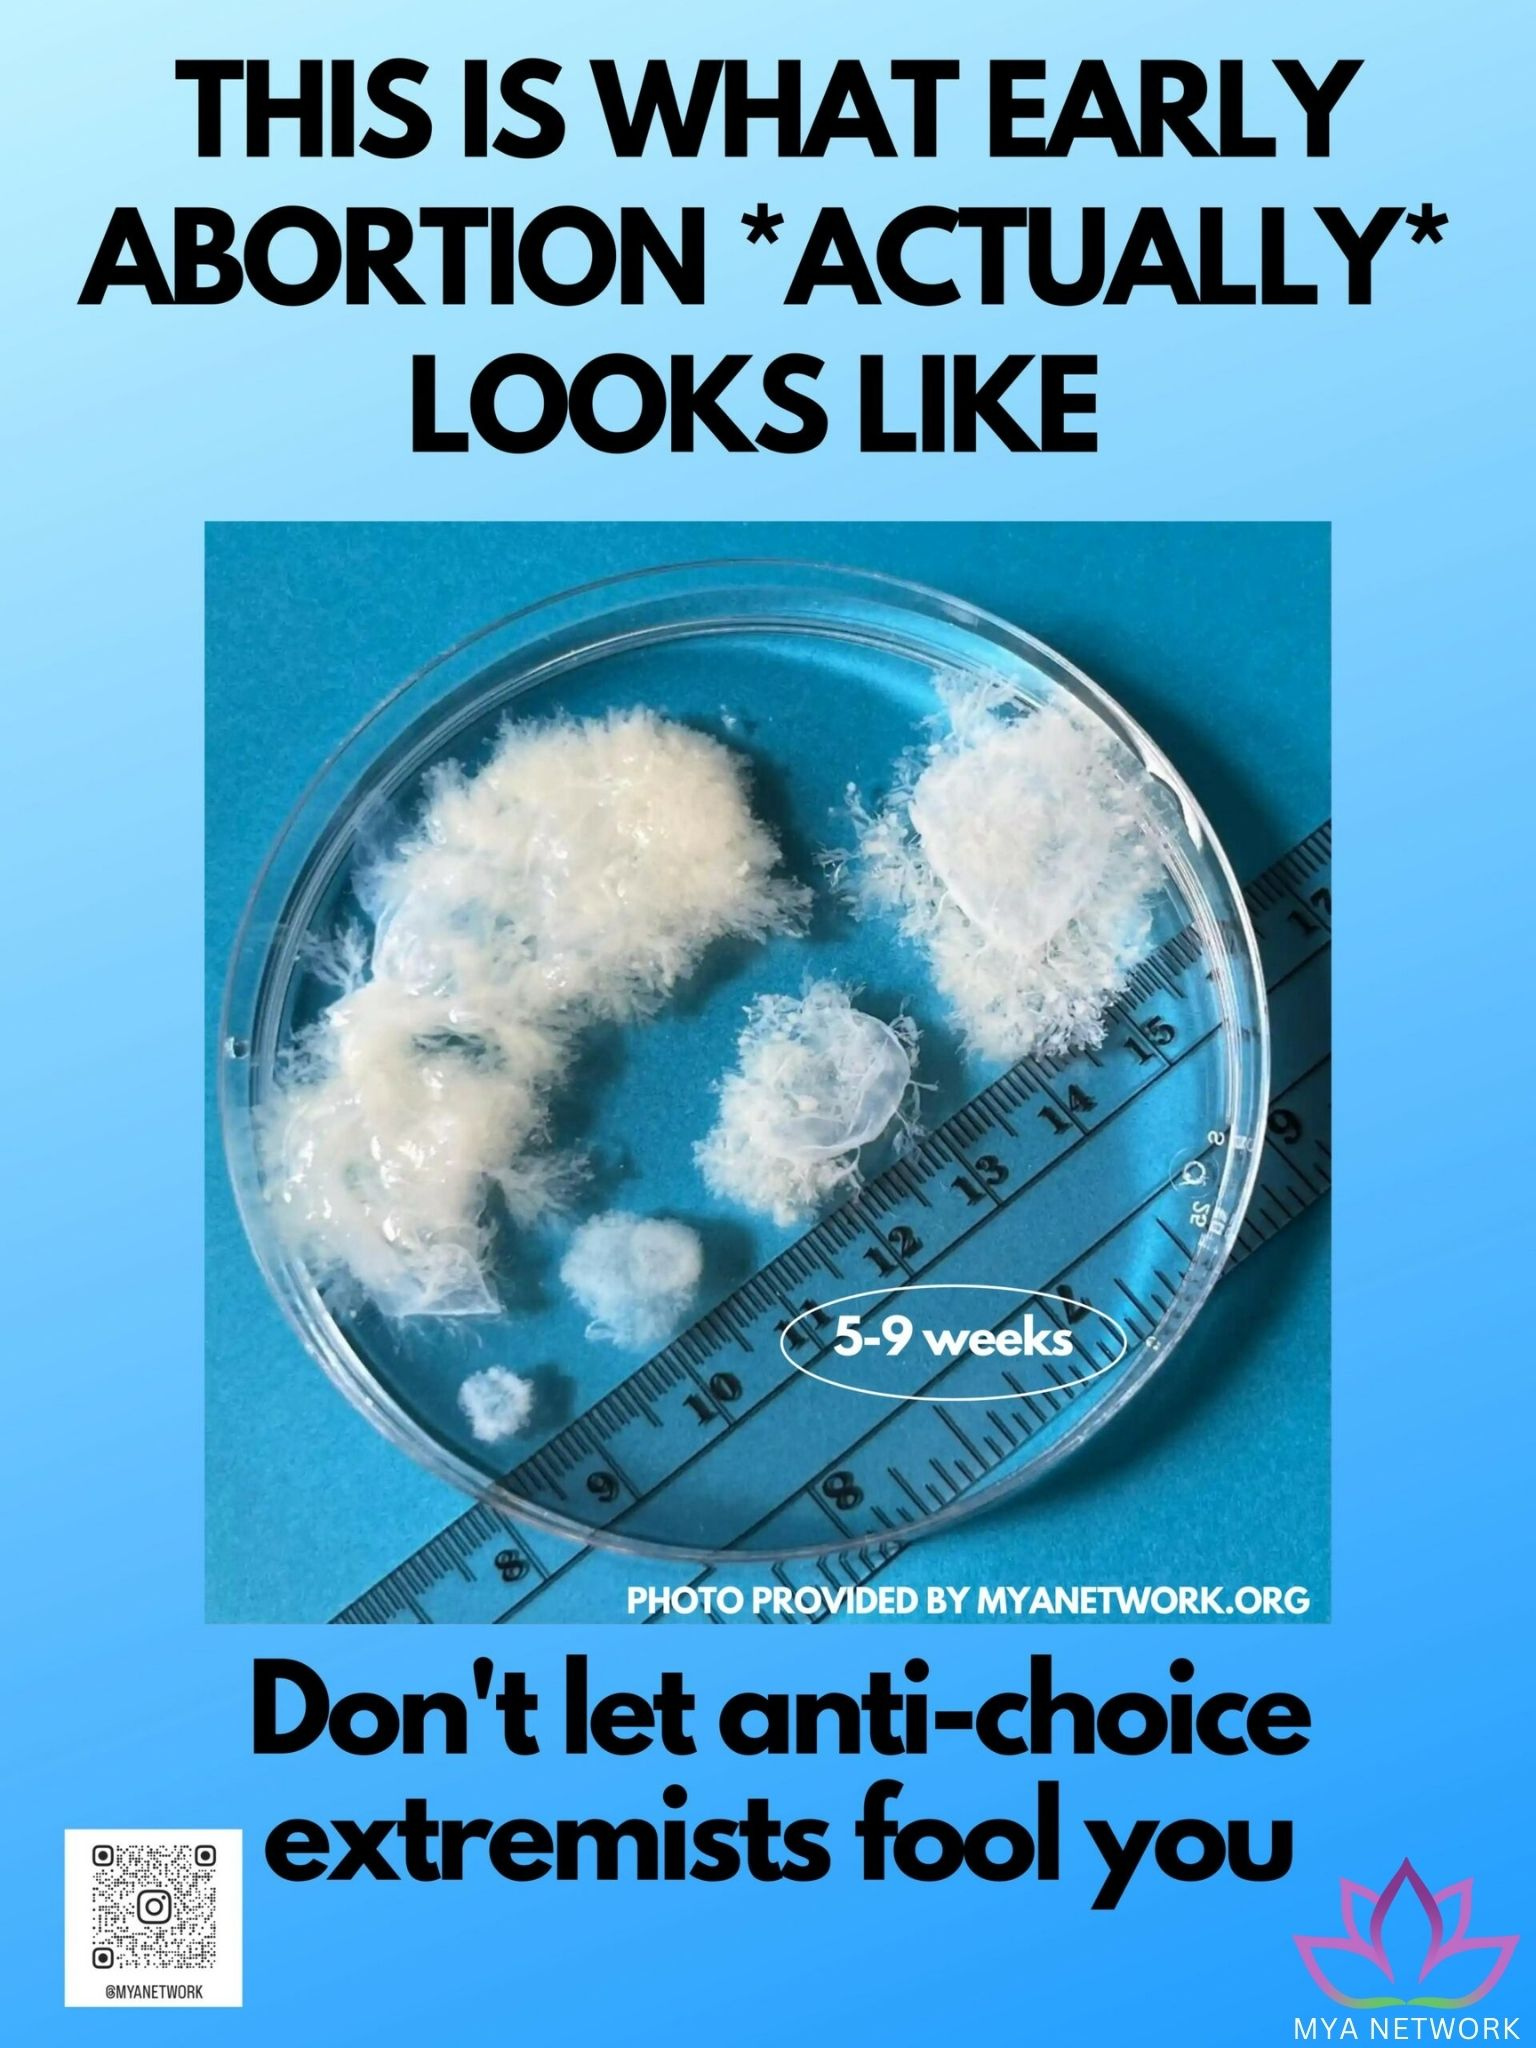

Abortion Facts
There are a lot of misconceptions and misinformation around abortion, especially spread by anti-abortion efforts. Here are some key facts to know:
The vast majority, 93%, of abortions occur during the first trimester at, or before, 13 weeks of gestation. (CDC)
 Visit the myanetwork for more information
Visit the myanetwork for more information
Another 6% of abortions occur between 14-20 weeks of pregnancy. (CDC)
Only 1% of abortion are performed at 21 weeks or more of gestation. And those are usually cases of severe medical complications. (CDC)
6 in 10 women who’ve had abortions already have children. (CDC)
1 in 4 U.S. women will have an abortion in their lifetimes. (Guttmacher Institute)
Abortion is safe: safer than carrying a pregnancy to term. (NASEM 2018)